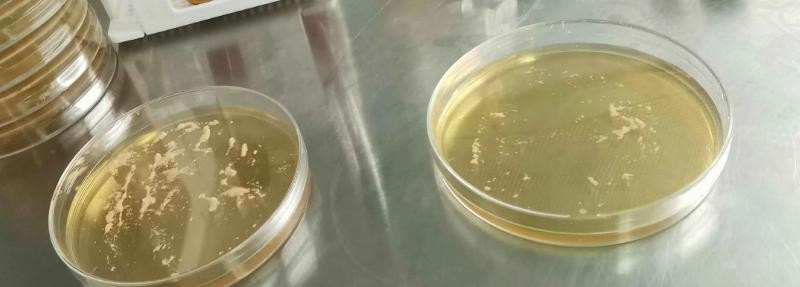

你是否曾为辛苦培养的菌种不易保存而苦恼?
想要一个既经济又实用的方法让你的菌种安全度过“寒冬”?
今天,我们就来揭开菌种保存的秘密武器——甘油保藏法的神秘面纱,从科学原理到具体操作,带你全面掌握这项实验室必备技能。
甘油,这种常见的化学物质,在菌种保存中扮演着重要的角色。
它就像一个保护罩,在低温环境下,保护着微生物细胞免受冰晶的伤害。
低温冷冻会使微生物的新陈代谢活动几乎停滞,而甘油的存在则能防止细胞内水分结冰,从而避免细胞结构的破坏,让菌种能够长期存活。
甘油的浓度并非越高越好,最佳浓度通常控制在10-20%。
这是因为高浓度的甘油过于粘稠,不利于与菌液混合均匀,反而可能影响保藏效果。
实际操作中,我们会先将高浓度甘油配制成50%的甘油水溶液,再与菌悬液以1:1的比例混合,确保甘油的最终浓度在合适的范围内。

除了甘油浓度,菌液本身的浓度也会影响保藏效果。
一般来说,菌液浓度越高,菌种的保存时间也就越长。
对于细菌,我们通常使用菌液进行保藏;而对于霉菌,则多采用无菌水或生理盐水制备的孢子悬液。
保存温度也是影响菌种存活的关键因素。
温度越低,微生物的代谢活动越缓慢,保藏效果也就越好。
通常情况下,我们会将菌种保存在-20℃,甚至更低的-70℃到-80℃的冰箱中,以达到长期保存的目的。
选择合适的培养基也至关重要。
为了确保保藏的菌种特性与原始菌株一致,我们建议使用非选择性增菌培养基。
因为在选择性培养基中,微生物为了适应环境,可能会丢失某些重要的生物学特性,导致保藏后的菌种与标准菌株出现差异。

了解了甘油保藏的原理,接下来我们就来看看具体的实验步骤。
我们需要准备好实验所需的各种工具:镊子、EP管、枪头、高压灭菌锅、试剂盒、移液枪、甘油、待保藏的菌种、保存袋以及标签。
在实验开始前,我们需要将镊子、EP管和枪头等放入高压灭菌锅中进行彻底的灭菌处理,确保实验环境的无菌性。
接下来,我们需要对双手和镊子进行酒精消毒。
用酒精擦拭双手,并用酒精棉球擦拭镊子,确保操作过程的无菌。
然后,用消毒后的镊子从试剂盒中取出所需的EP管。
现在,我们可以开始制备甘油菌液了。
用移液枪吸取配制好的50%甘油溶液,将其加入到EP管中。
然后,再用移液枪吸取待保藏的菌悬液,将其与甘油溶液混合均匀。

确保菌悬液和甘油溶液的体积比例为1:1,使甘油的最终浓度控制在理想范围内。
将甘油和菌液混合后,盖上EP管的盖子,并做好标记。
清晰的标记是后续实验顺利进行的关键,它可以帮助我们快速准确地找到所需的菌种。
将所有标记好的EP管装入保存袋中,并在袋子上也做好标记,以便于管理和查找。
将装有菌种的保存袋放入-20℃的冰箱中进行低温保存。
如果需要更长期的保存,可以考虑将菌种保存在-70℃到-80℃的超低温冰箱中。
甘油保藏法是一种经济实用的菌种保存方法,适用于中长期(2-4年)的菌种保存。
但需要注意的是,即使在低温环境下,菌种的活力也会随着时间的推移而逐渐下降。
因此,对于需要长期保存的菌种,建议定期进行复苏和传代,以保持菌种的活性。

除了甘油保藏法,还有其他一些菌种保存方法,例如冷冻干燥法、液氮保藏法等。
不同的保存方法各有优缺点,适用于不同的菌种和保存需求。
选择合适的保存方法,才能更好地保护珍贵的菌种资源。
那么,你还有什么其他的菌种保存妙招吗?
欢迎在评论区留言分享你的经验和见解。